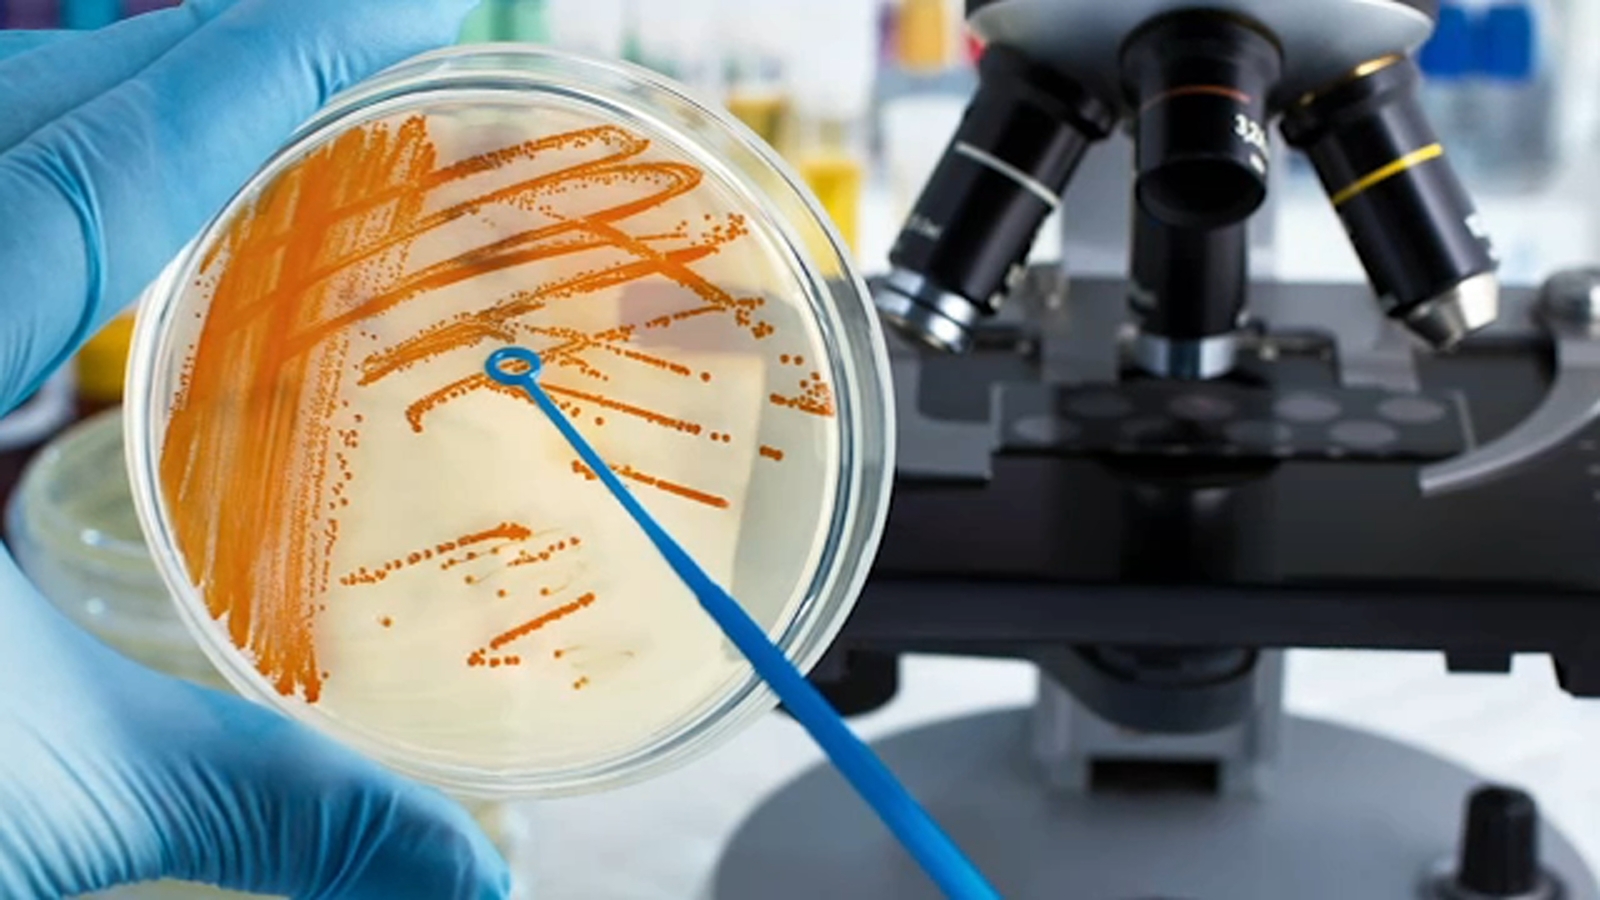

Unusual Spike in Invasive Strep Cases Raises Concerns for Parents
Doctors at the Medical University of South Carolina have reported a spike in cases of Invasive Group A Strep, a more aggressive and severe form of the bacteria that causes Strep throat. The increase is considered "very, very unusual" and may be due to reduced exposure during the pandemic or a cluster of cases that would normally occur over a longer period. Parents are advised to seek medical care early if their child shows signs of a high fever, muscle aches, or chills, as early treatment with antibiotics can prevent the infection from progressing to a more severe stage.